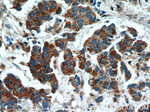
SMOX Antibody in Immunohistochemistry (Paraffin) (IHC (P))

Search
Proteintech
SMOX Polyclonal Antibody
{{$productOrderCtrl.translations['antibody.pdp.commerceCard.promotion.promotions']}}
{{$productOrderCtrl.translations['antibody.pdp.commerceCard.promotion.viewpromo']}}
{{$productOrderCtrl.translations['antibody.pdp.commerceCard.promotion.promocode']}}: {{promo.promoCode}} {{promo.promoTitle}} {{promo.promoDescription}}. {{$productOrderCtrl.translations['antibody.pdp.commerceCard.promotion.learnmore']}}
产品信息
15052-1-AP
种属反应
已发表种属
宿主/亚型
分类
类型
抗原
偶联物
形式
浓度
规格
纯化类型
保存液
内含物
保存条件
运输条件
产品详细信息
Immunogen sequence: MQSCESSGD SADDPLSRGL RRRGQPRVVV IGAGLAGLAA AKALLEQGFT DVTVLEASSH IGGRVQSVKL GHATFELGAT WIHGSHGNPI YHLAEANGLL EETTDGERSV GRISLYSKNG VACYLTNHGR RIPKDVVEEF SDLYNEVYNL TQEFFRHDKP VNAESQNSVG VFTREEVRNR IRNDPDDPEA TKRLKLAMIQ QYLKVESCES SSHSMDEVSL SAFGEWTEIP GAHHIIPSGF MRVVELLAEG IPAHVIQLGK PVRCIHWDQA SARPRGPEIE P (1-280 aa encoded by BC000669)
靶标信息
Polyamines are ubiquitous polycationic alkylamines which include spermine, spermidine, putrescine, and agmatine. These molecules participate in a broad range of cellular functions which include cell cycle modulation, scavenging reactive oxygen species, and the control of gene expression. These molecules also play important roles in neurotransmission through their regulation of cell-surface receptor activity, involvement in intracellular signalling pathways, and their putative roles as neurotransmitters. This gene encodes an FAD-containing enzyme that catalyzes the oxidation of spermine to spermadine and secondarily produces hydrogen peroxide. Multiple transcript variants encoding different isoenzymes have been identified for this gene, some of which have failed to demonstrate significant oxidase activity on natural polyamine substrates.
仅用于科研。不用于诊断过程。未经明确授权不得转售。
生物信息学
蛋白别名: flavin containing amine oxidase; flavin-containing amine oxidase; flavin-containing spermine oxidase; PAO-1; Polyamine oxidase 1; putative cyclin G1 interacting protein; Spermine oxidase; unnamed protein product
基因别名: B130066H01Rik; C20orf16; PAO; PAO-1; PAO1; PAOH; PAOH1; SMO; SMOX; UNQ3039/PRO9854
UniProt ID: (Human) Q9NWM0, (Mouse) Q99K82
Entrez Gene ID: (Human) 54498, (Mouse) 228608, (Rat) 308652